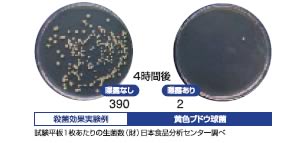

除菌・消臭に |
|
お問い合わせ・資料請求 |
| |
常時設置タイプ
低濃度オゾンを常時発生することで細菌の繁殖を防止します |
|
| |
|
エアフィーノ VS-40
インテリア性の高いデザインの室内用オゾン発生器
最大120㎡(35坪)まで対応可能
オゾン発生量: 2.5/5/10/20/40mg/h(5段階切り替え)
外寸: 251(W)x82.5(D)x250.2(H)mm
重量: 本体1.2kg
価格: 180,000円
|
|
| |
|
エアエッセンス VR-40
小規模スペースに優れた効果を発揮するオゾン発生器
オゾン発生量: 2.5/5/10/20/40mg/h(5段階切り替え)
外寸: 150(W)x90(D)x170(H)mm
重量: 本体1.4kg
価格: 180,000円
|
|
| |
|
クリーンブロー CB-20
トイレ、病室等に最適な小型オゾン発生器
オゾン発生量: 5/10/20mg/h(3段階切り替え)
外寸: 150(W)x90(D)x170(H)mm
重量: 本体約800g
価格:
128,000円
|
|
| |
|
爽やかイオンプラス CS-4(3色のボデーカラー)
(ホワイトピンク CS-4P, ブルー CS-4, ブルーグレー CS-4G)
低濃度オゾンで爽やかな空間に
10畳程度までのお部屋に最適なオゾン発生器
オゾン発生量: 1、2、4mg/hの3段階切り替え
外寸: 90(W)x70(D)x170(H)mm
重量: 本体約320g
価格: 37,000円
|
|
| |
 |
エアスペイサー AS-50
狭いスペースにもご利用頂けるチューブ装着オゾン供給装置
オゾン発生量: 10/20/30/40/50mg/h(5段階切り替え)
外寸: 115(W)x320(D)x210(H)mm
重量: 本体約4kg
価格: 220,000円
|
|
| |
短時間で強力に除菌します
高濃度オゾンを短時間薫蒸することで室内の空気を除菌します |
|
| |
 |
剛腕1000 GWD-1000T、 GWD-1000F
プログラムタイマー付 GWD-1000T
オフタイマー付 GWD-1000F
ホテル客室ツインルームなら15分程度で強力に除菌・消臭します。
推奨適用広さ: ~130㎡(40坪)
オゾン発生量: 250/500/750/1000mg/h(4段階切り替え)
外寸: 340(W)x200(D)x202(H)mm
重量: 本体約6kg
価格: 385,000円
|
|
| |
 |
剛腕500 GWN-500
オフタイマー付き
ホテルの客室やカラオケルーム、自動車等約20坪までの様々な場所での除菌に。ホテルツインルームなら約20分で除菌・消臭します
推奨適用広さ: ~70㎡(20坪)
オゾン発生量: 500mg/h
外寸: 302(W)x160(D)x176(H)mm
重量: 本体約4.5kg
価格: 285,000円
|
|
| |
 |
剛腕300 GWN-300CT
オフタイマー付き
3電源100~240V(専用ACアダプター使用)、DC12/24V(シガライターより)で様々な場所で対応可能
自動車、ホテル客室、会議室、カラオケルームなどでの除菌・消臭に
推奨適用広さ: ~40㎡(12坪)
オゾン発生量: 300mg/h
外寸: 310(W)x170(D)x140(H)mm
重量: 本体3kg
価格: 198,000円
|
|
| |
|
|
|

![]()



